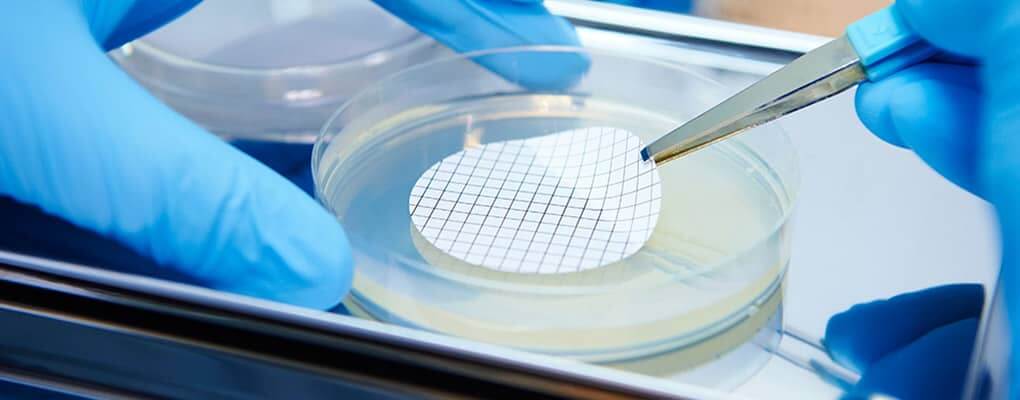
Patented Manufacturing Method Achieves Exceptionally High Hydrogen Concentration

Why Nano Hydrogen Water? Why KIYORABI?
Why is nano hydrogen water
good for the body?
Nano Hydrogen Water KIYORABI
In the seven years since production began, more than 12 million bottles of this
nano hydrogen water originating in Japan have been produced.
Made entirely from Kumamoto spring water

KIYORABI is made from the ground water of Kikuchi City, Kumamoto Prefecture, Kyushu, which was selected as one of the hundred exquisite waters of Japan. We wanted KIYORABI to be easy to drink and to taste pleasant. We also publish all water quality test results.
Safe and secure manufacturing process

Our manufacturing plant obtained certification to ISO 22000:2005, an international standard that defines the requirements of a food safety management system. All the products we deliver to our customers are subject to strict quality controls throughout the entire process from manufacturing to packaging and shipment.
Special aluminum container
that reduces hydrogen discharge

Hydrogen will eventually escape from a plastic or glass bottle. We used an aluminum container that reduces hydrogen discharge and, after many improvements, we have developed a specially designed pouch that can preserve the original clear taste of water.
Patented manufacturing method achieves
exceptionally high hydrogen concentration
We use a patented manufacturing method, which involves injecting hydrogen into the ground water with high pressure, to pack the water full of hydrogen. We also use our patented SPG membrane to further reduce hydrogen discharge and maintain a high concentration of hydrogen.
Our miraculous KIYORABI hydrogen water has a proven track record of boosting health and beauty. Made in Japan, it is also high quality. Try it for yourself!

Nano Hydrogen WaterKIYORABIStart with a pouch a day!
- 500 ml x 30 pcs
- We ship freshly made products with a 4-month expiration date
(from the date of manufacture). - Storage : Store in a cool, dark place, away from sunlight and heat.
- Free Shipping
*Domestic oder(Delivery within Singapore).
*Avoid squeezing the container when opening the cap, as this will cause the water to spill out.